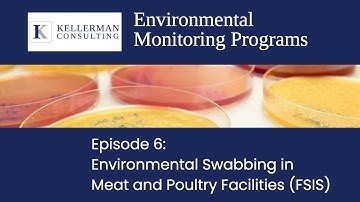
Episode 6: Environmental Monitoring Programs in Meat & Poultry Facilities (FSIS)

⬇ DOWNLOAD NOW
Kalau muncul iklan pop-up, tutup lalu klik tombol kembali
Download lagu The FSIS Appendix A/B - How Data Loggers Can Help secara gratis hanya untuk keperluan promosi. Dukung artis favorit kamu dengan membeli musik original di iTunes atau platform resmi lainnya.
 FSIS Appendix A and B Updates
FSIS Appendix A and B Updates
 FSIS - DTR HAP Side (How To Video)
FSIS - DTR HAP Side (How To Video)
 FSIS Salmonella Initiative
FSIS Salmonella Initiative
Episode 6: Environmental Monitoring Programs in Meat & Poultry Facilities (FSIS)
Episode 6: Environmental Monitoring Programs in Meat & Poultry Facilities (FSIS)
 Appendix A - Training Video
Appendix A - Training Video
 Fsis
Fsis
 Appendix B, Video 3
Appendix B, Video 3
 Cooking & Cooling Video Series Part Three: Fermented Products
Cooking & Cooling Video Series Part Three: Fermented Products